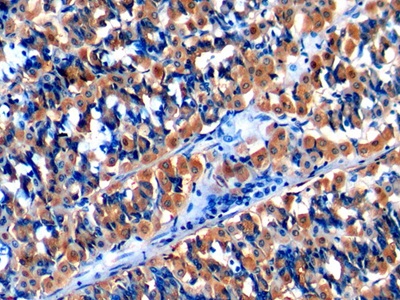

Polyclonal Antibody to Monocyte Chemotactic Protein 1 (MCP1) 

CCL2; GDCF2; HC11; HSMCR30; MCAF; MCP1; SCYA2; SMC-CF; Chemokine C-C-Motif Ligand 2; Monocyte Chemotactic And Activating Factor; Monocyte Secretory Protein JE
Overview
Properties
- Product No.PAA087Hu01
- Organism SpeciesHomo sapiens (Human) Same name, Different species.
- ApplicationsIHC
If the antibody is used in flow cytometry, please check FCM antibodies.
Research use only - DownloadInstruction Manual
- CategoryCytokineTumor immunityInfection immunity
- SourcePolyclonal antibody preparation, Host Rabbit
- Ig Type IgG, Potency n/a
- PurificationAntigen-specific affinity chromatography followed by Protein A affinity chromatography
- LabelNone
- Immunogen RPA087Hu01-Recombinant Monocyte Chemotactic Protein 1 (MCP1)
- Buffer Formulation0.01M PBS, pH7.4, containing 0.05% Proclin-300, 50% glycerol.
- TraitsLiquid, Concentration 0.5mg/mL
Sign into your account
Share a new citation as an author
Upload your experimental result
Review

Contact us
Please fill in the blank.
Specifity
The antibody is a rabbit polyclonal antibody raised against MCP1. It has been selected for its ability to recognize MCP1 in immunohistochemical staining and western blotting.
Usage
Immunohistochemistry: 5-20µg/mL;
Optimal working dilutions must be determined by end user.
Storage
Store at 4°C for frequent use. Stored at -20°C in a manual defrost freezer for two year without detectable loss of activity. Avoid repeated freeze-thaw cycles.
Stability
The thermal stability is described by the loss rate. The loss rate was determined by accelerated thermal degradation test, that is, incubate the protein at 37°C for 48h, and no obvious degradation and precipitation were observed. The loss rate is less than 5% within the expiration date under appropriate storage condition.
Giveaways
Increment services
-
 Antibody Labeling Customized Service
Antibody Labeling Customized Service
-
 Protein A/G Purification Column
Protein A/G Purification Column
-
 Staining Solution for Cells and Tissue
Staining Solution for Cells and Tissue
-
 Positive Control for Antibody
Positive Control for Antibody
-
 Tissue/Sections Customized Service
Tissue/Sections Customized Service
-
 Phosphorylated Antibody Customized Service
Phosphorylated Antibody Customized Service
-
 Western Blot (WB) Experiment Service
Western Blot (WB) Experiment Service
-
 Immunohistochemistry (IHC) Experiment Service
Immunohistochemistry (IHC) Experiment Service
-
 Immunocytochemistry (ICC) Experiment Service
Immunocytochemistry (ICC) Experiment Service
-
 Flow Cytometry (FCM) Experiment Service
Flow Cytometry (FCM) Experiment Service
-
 Immunoprecipitation (IP) Experiment Service
Immunoprecipitation (IP) Experiment Service
-
 Immunofluorescence (IF) Experiment Service
Immunofluorescence (IF) Experiment Service
-
 Buffer
Buffer
-
 DAB Chromogen Kit
DAB Chromogen Kit
-
 SABC Kit
SABC Kit
-
 Long-arm Biotin Labeling Kit
Long-arm Biotin Labeling Kit
-
 Real Time PCR Experimental Service
Real Time PCR Experimental Service
Citations
- Astragaloside IV ameliorates renal injury in streptozotocin-induced diabetic rats through inhibiting NF-κB-mediated inflammatory genes expression.Pubmed: 23434274
- Serum levels of selected chemokines in systemic lupus erythematosus patientsPubmed: 22461186
- Effects of Hyriopsis cumingii polysaccharides on angiogenesis, macrophage chemotaxis, proliferation and phagocytosisPubmed:25620195
- MRTF-A steers an epigenetic complex to activate endothelin-induced pro-inflammatory transcription in vascular smooth muscle cellsPubmed:Pmc4176337
- Adipose tissue chromium and vanadium disbalance in high-fat fed Wistar ratsPubmed:25194956
- 巨噬细胞及其相关因子在家兔不稳定斑块中的作用及其机制Paper:Source
- Rosiglitazone attenuates renal injury caused by hyperlipidemic pancreatitisPubMed: 26191125
- Effects of Intravenous Injection ofPubMed: 26063970
- Protein Inhibitor of Activated STAT 1 (PIAS1) Protects Against Obesity-Induced Insulin Resistance by Inhibiting Inflammation Cascade in Adipose TissuePubMed: 26324179
- Epigallocatechin-3-Gallate Attenuates Unilateral Ureteral Obstruction-Induced Renal Interstitial Fibrosis in MicePubMed: 25549657
- MicroRNA-155 Promotes Atherosclerosis Inflammation via Targeting SOCS1PubMed: 26159489
- Renoprotective effects of angiotensin receptor blocker and stem cells in acute kidney injury: Involvement of inflammatory and apoptotic markersPubMed: 25825359
- Trypanosoma cruzi infection and benznidazole therapy independently stimulate oxidative status and structural pathological remodeling of the liver tissue in micePubMed: 25912691
- Simultaneous Increase in Multiple Proinflammatory Cytokines in the Aqueous Humor in Neovascular Glaucoma With and Without Intravitreal Bevacizumab InjectionPubMed: 26030108
- Postoperative changes in aqueous monocyte chemotactic protein-1 levels and bleb morphology after trabeculectomy vs. Ex-PRESS shunt surgeryPubMed: 26427058
- Expression of adhesion molecules, chemokines and matrix metallo- proteinases (MMPs) in viable and degenerating stage of Taenia solium metacestode in swine neurocysticercosisPubMed: 26412140
- Modulation of oxidative and inflammatory cardiac response by nonselective 1‐and 3‐cyclooxygenase inhibitor and benznidazole in micePubMed: 26105112
- НАРУШЕНИЕ БАЛАНСА ХРОМА И ВАНАДИЯ В ЖИРОВОЙ ТКАНИ КАК ВОЗМОЖНЫЙ МЕХАНИЗМ ОЖИРЕНИЕ-АССОЦИИРОВАННОЙ ИНСУЛИНОРЕЗИСТЕНТНОСТИMicroelements_Of_Midicine: 2015_2
- The G-Protein-Coupled Bile Acid Receptor Gpbar1 (TGR5) Inhibits Gastric Inflammation Through Antagonizing NF-κB Signaling PathwayPubMed: 26696888
- Effects of PB-EPCs on Homing Ability of Rabbit BMSCs via Endogenous SDF-1 and MCP-1.PubMed: 26660527
- The Transcriptional Foundations of Sp110-mediated Macrophage (RAW264. 7) Resistance to Mycobacterium tuberculosis H37RaPubmed:26912204
- Fractalkine Attenuates Microglial Cell Activation Induced by Prenatal StressPubmed:27239349
- Decreased adipose tissue zinc content is associated with metabolic parameters in high fat fed Wistar ratsabstract:10
- Consistency and pathophysiological characterization of a rat polymicrobial sepsis model via the improved cecal ligation and puncture surgeryPubmed:26802602
- Anti‐inflammatory properties of tianeptine on lipopolysaccharide‐induced changes in microglial cells involve toll‐like receptor‐related pathwaysPubmed:26640965
- Hyperglycemia Aggravates Hepatic Ischemia Reperfusion Injury by Inducing Chronic Oxidative Stress and Inflammation.pubmed:27656261
- Identification of some plasma biomarkers associated with early weaning stress in crossbred pigletsarticle:10.1007
- The serum concentrations of leptin and MCP-1 independently predict low back pain duration.pubmed:28076310
- oxLDL antibody inhibits MCP‐1 release in monocytes/macrophages by regulating Ca2+/K+ channel flowpubmed:27995732
- Nonsteroidal anti-inflammatory is more effective than anti-oxidant therapy in counteracting oxidative/nitrosative stress and heart disease in T. cruzi-infected mice.pubmed:28134069
- Adhesion molecules, chemokines and matrix metallo-proteinases response after albendazole and albendazole plus steroid therapy in swine neurocysticercosispubmed:28821422
- Role of Gut-Derived Endotoxin on Type I Collagen Production in the Rat Pancreas after Chronic Alcohol Exposure pubmed:29121396
- BuShenKangShuai tablet reduces atherosclerotic lesion by improving blood lipids metabolism and inhibiting inflammatory response via TLR4 and NF-κB signaling pathwayjournals:1758383
- Protective effect of high mobility group box-1 silence on diabetic retinopathy: an in vivo studyISSN:1936-2625/IJCEP0055881
- An ALOX12-12-HETE-GPR31 signaling axis is a key mediator of hepatic ischemia-reperfusion injury.pubmed:29227475
- STAT3-RXR-Nrf2 activates systemic redox and energy homeostasis upon steep decline in pO2 gradient.pubmed:29078168
- The deubiquitinating enzyme cylindromatosis mitigates nonalcoholic steatohepatitisPubmed:29291351
- Molybdenum disulfide/graphene oxide nanocomposites show favorable lung targeting and enhanced drug loading/tumor-killing efficacy with improved …Articles:am2017225
- Metformin attenuates effects of cyclophilin A on macrophages, reduces lipid uptake and secretion of cytokines by repressing decreased AMPK activityPubmed:29382697
- Lipoxin A4 may attenuate the progression of obesity-related glomerulopathy by inhibiting NF-κB and ERK/p38 MAPK-dependent inflammationPubmed:29499280
- Bushenkangshuai Tablet Reduces Atherosclerotic Lesion by Improving Blood Lipids Metabolism and Inhibiting Inflammatory Response via TLR4 and NF-κB Signaling …Pubmed:29619063
- Evaluation of the therapeutic effect of micro-plasma radio frequency on hypertrophic scars in rabbit earsPubmed:30003425
- Effect of 0.05% Difluprednate Ophthalmic Emulsion on Proinflammatory Cytokine Levels After Retinal Laser Photocoagulation in RabbitsPubmed:29812993
- Increased Serum MCP-1 Levels in Systemic Vasculitis Patients with Renal InvolvementPubmed: 30230985
- Detoxification and activating blood circulation decoction reduces restenosis involving the TLR4/NF-κB pathway after balloon injuryPubmed: 30453089
- Role of Chronic Administration of Antidepressant Drugs in the Prenatal Stress-Evoked Inflammatory Response in the Brain of Adult Offspring Rats …Pubmed: 30610610
- Long non-coding RNA mitigates atherosclerosis by regulating the actin-binding protein NEXNPubmed: 30589415
- Wnt/β-catenin signaling mediates both heart and kidney injury in type 2 cardiorenal syndromePubmed: 30770217
- A sensitive sandwich-type immunosensor for the detection of MCP-1 based on a rGO-TEPA-Thi-Au nanocomposite and novel RuPdPt trimetallic nanoalloy particles
- The cordycepin derivative IMM-H007 improves endothelial dysfunction by suppressing vascular inflammation and promoting AMPK-dependent eNOS activation in …Pubmed: 30826323
- Effect of stress hyperglycaemia on monocyte chemoattractant protein‑1 levels and the short‑term prognosis of patients with acute ST‑segment elevation myocardial …
- Integrated Omics Reveals Tollip as an Aggravator and Therapeutic Target for Hepatic Ischemia‐Reperfusion Injury in MicePubmed: 31077413
- Rescuing cones and daylight vision in retinitis pigmentosa micePubmed: 31199887
- Lanthanum chloride induces neuron damage by activating the nuclear factor-kappa B signaling pathway in activated microgliaPubmed: 31187842
- Hepatocyte TRAF 6 Aggravates Hepatic Inflammation and Fibrosis by Promoting Lys6‐Linked Polyubiquitination of ASK 1
- LncRNA HOXA11‐AS regulates calcium oxalate crystal–induced renal inflammation via miR‐124‐3p/MCP‐1Pubmed: 31680444
- Histone H3 serine 10 phosphorylation facilitates endothelial activation in diabetic kidney diseasePubmed: 30213824
- Inhibition of CXCL1-CXCR2 axis ameliorates cisplatin-induced acute kidney injury by mediating inflammatory responsePubmed: 31812015
- α-Galactosylceramide and its analog OCH differentially affect the pathogenesis of ISO-induced cardiac injury in micePubmed: 32973325
- Modulating endothelial adhesion and migration impacts stem cell therapies efficacyPubmed: 32942121
- Sea cucumbers-derived sterol sulfate alleviates insulin resistance and inflammation in high-fat-high-fructose diet-induced obese micePubmed: 32911073
- A novel apoA‐I mimetic peptide suppresses atherosclerosis by promoting physiological HDL function in apoE−/− micePubmed: 32726461
- BNIP3 deletion ameliorated enterovirus 71 infection-induced hand, foot and mouth disease via inhibiting apoptosis, autophagy, and inflammation in micePubmed: 32717566
- Impact of diminazene aceturate on renin-angiotensin system, infectious myocarditis and skeletal myositis in mice: An in vitro and in vivo studyPubmed: 32652140
- Curcumin and LOXblock-1 ameliorate ischemia-reperfusion induced inflammation and acute kidney injury by suppressing the semaphorin-plexin pathway.Pubmed: 32603817
- Aquaporin‑4 deletion ameliorates enterovirus 71 infection in micePubmed: 32582978
- Protective function of exosomes from adipose tissue-derived mesenchymal stem cells in acute kidney injury through SIRT1 pathwayPubmed: 32428599
- β-Defensin Strengthens Antimicrobial Peritoneal Mast Cell ResponsePubmed: 32411798
- Low-Dose Sorafenib Acts as a Mitochondrial Uncoupler and Ameliorates Nonalcoholic SteatohepatitisPubmed: 32375062
- Protective Effects of Carbon Dots Derived from Phellodendri Chinensis Cortex Carbonisata against Deinagkistrodon acutus Venom-Induced Acute Kidney …
- Effects of regular exercise on inflammatory biomarkers and lipid parameters in soccer players33750257
- Cyclophilin A induces macrophage apoptosis and enhances atherosclerotic lesions in high©\fat diet©\fed hyperglycemic rabbits33977232
- TNIP3 is a novel activator of Hippo©\YAP signaling protecting against hepatic ischemia/reperfusion injury34133792
- Construction of heparin-based hydrogel incorporated with Cu5. 4O ultrasmall nanozymes for wound healing and inflammation inhibition33778192
- p62 promotes HIV-1 gp120 V3 loop-mediated microglial inflammation by promoting noncanonical activation of Nrf2
- Intraocular Pressure-Lowering Effects of Trabeculectomy Versus MicroShunt Insertion in Rabbit Eyes34357381
- Pharmacological inhibition of arachidonate 12-lipoxygenase ameliorates myocardial ischemia-reperfusion injury in multiple species34536344
- CCL2 (CC Motif Chemokine Ligand 2) Biomarker Responses in Central Versus Peripheral Compartments After Focal Cerebral Ischemia34587791
- Identification of potential regulating effect of baicalin on NFκB/CCL2/CCR2 signaling pathway in rats with cerebral ischemia by antibody-based array and …34699947
- Huangbai liniment and berberine promoted wound healing in high-fat diet/Streptozotocin-induced diabetic ratsPubmed:35430394
- Dapagliflozin mitigates ovalbumin-prompted airway inflammatory-oxidative successions and associated bronchospasm in a rat model of allergic asthmaPubmed:35549595